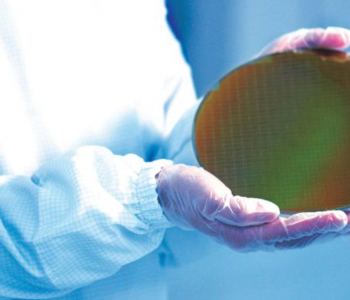

Блог Mirakl
всего записей -
4577
Блог Mirakl
всего записей -
4577
всего записей -
4577
Спутник ERS-2 вернется на Землю после 29 лет пребывания в космосе
Спутник ERS-2, завершивший миссию по наблюдению за Землей 13 лет назад, скоро войдет в атмосферу Земли в неконтролируемом состоянии
Ученые разработали концепцию строительства убежищ на Луне по образцу термитников
Инженеры из Университета Аризоны разработали концепцию строительства жилища на Луне с помощью умных мешков с песком
Проходящие мимо Солнечной системы звезды изменяют орбиту Земли и влияют на климат
Астрономы обнаружили, что звезды, проходящие мимо Солнечной системы, могут влиять на орбиты планет, включая Землю, что, в свою очередь, влияет на изменения климата.
Ученые разработали антибиотик с высокой эффективностью против устойчивых к лекарствам бактерий
Убийца супербактерий: новая синтетическая молекула, высокоэффективная против устойчивых бактерий
Исследователи из Университета RMIT используют наноалмазы для создания умного текстиля
Наноалмазы могут стать ключом к созданию крутой одежды, которая сможет быстрее охлаждать людей.
Google представила систему киберзащиты "Magika" на основе искусственного интеллекта
Google представил новую систему киберзащиты "Magika", использующую искусственный интеллект для обнаружения и блокировки вредоносных программ с высокой точностью.
Jackery представила новый солнечный генератор и запустила программу по обмену старых моделей
Компания Jackery хочет стать еще более экологичной: производитель представил первую электростанцию, изготовленную из переработанного пластика, а также предлагает отремонтированные модели
На выставке MWC компания Xiaomi представит международной аудитории электромобиль SU7
Xiaomi готовит сюрприз на MWC: впервые покажет электромобиль за пределами Китая
Ученые предложили новую теорию "матрешки" для гравастаров
Ученые из Университета Гёте предложили новую теорию гравастаров, предполагая, что они могут быть устроены подобно матрешкам, с одним гравастаром внутри другого.
Ученые приближают звезды к Земле, создавая новые изотопы
Международная научная команда в Мичиганском государственном университете создала пять новых изотопов, что открывает новые возможности для изучения процессов формирования элементов в космосе
Алексей Навальный внезапно умер в колонии
Как сообщили в управлении Федеральной службы исполнения наказаний, Навальному стало плохо и он практически сразу потерял сознание
Ученые зафиксировали, что золото становится крепче под воздействием интенсивных лазерных импульсов
Исследователи из SLAC обнаружили странное поведение золота под воздействием лазера
Исследование морфологии и минералогии Марса показало, что Красная планета была вулканически активной
Ученые пришли к выводу, что Марс был вулканически активен и переживал периоды обновления коры в начале своего существования
Samsung заключила соглашение с японским стартапом Preferred Networks на производство 2-нм чипов
Samsung выигрывает гонку за заказ на 2-нанометровые чипы у японского стартапа, опережая TSMC в борьбе за новые заказы.
Intel разрабатывает новый адаптивный фильтр повышения резкости для графики Xe2-LPG
Intel внедряет адаптивный фильтр улучшения резкости в свои будущие мобильные чипы Lunar Lake, обещая значительные улучшения в качестве изображений в играх и других приложениях.
ESA запускает спутник Solar Orbite для точного прогнозирования солнечных бурь
ESA запустила спутник Solar Orbiter для улучшения прогнозирования солнечных бурь, отправив его к точке Лагранжа L5.
Японский луноход SLIM отправил на Землю ценные данные о десяти лунных камнях
Это значительно превысило первоначальные ожидания ученых и может способствовать пониманию происхождения Луны.
Hyundai Ioniq 6 показывает отличный пробег на низких скоростях, но уступает на автостраде
В недавнем тесте на дальность Hyundai Ioniq 6 LR AWD показал высокую эффективность на низких и средних скоростях, но его результаты на высоких скоростях оказались ниже ожиданий
Samsung Galaxy Tab A9 выделяется на фоне конкурентов
Samsung Galaxy Tab A9, благодаря своему компактному дизайну, LTE поддержке и длительному сроку обслуживания, выделяется среди конкурентов в бюджетном сегменте планшетов.
NASA предположили, что космические сигналы могут быть связаны с внутренними процессами магнетаров
Наблюдения за магнетаром SGR 1935+2154 с помощью рентгеновских телескопов NASA NICER и NuSTAR раскрыли новые детали о происхождении быстрых радиовсплесков, показав, что эти космические явления могут быть связаны с изменениями скорости вращения и внутренними процессами магнетаров.